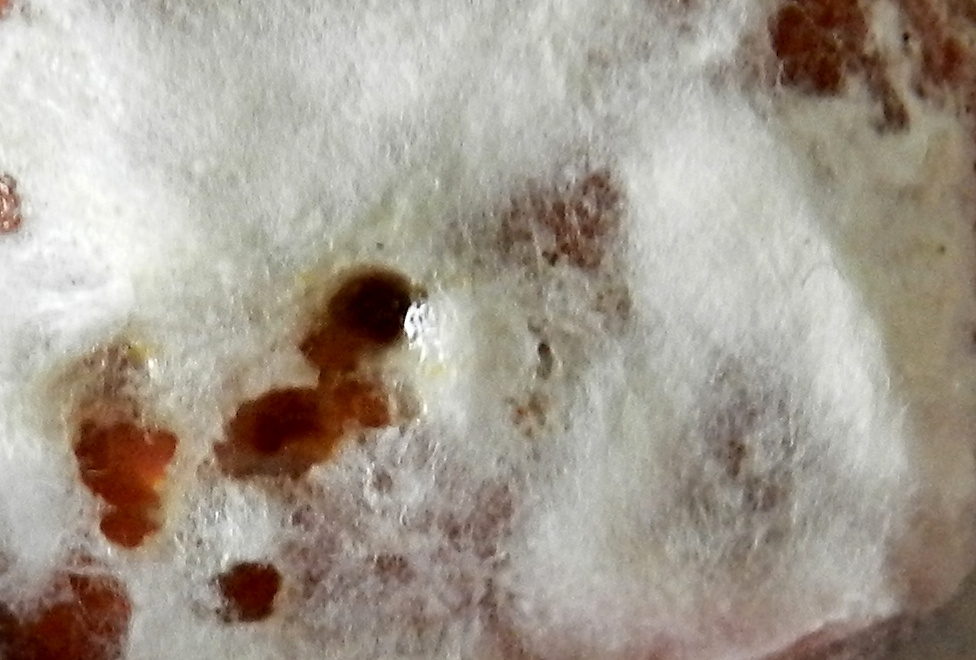

Další nabídka toho, co všichni znáte, jen se lépe podívat, zavzpomínat a už to máte...
8
komentářů
Dana Puchalská
24.6.2019 15:59
Jsou tam na obr. 3 červ na jablku, na obr. 2 nějaká plst či co a na obr. 1 semínka nebo ořechy nebo kulaté koření
Zdenka Soukupová
24.6.2019 15:26
Takže něco má naklíčit a místo toho to sežral červík?
Jarmila Nedvídková
24.6.2019 13:38
Ten stínový obrázek je jen záhlaví... ?-Co to je-smajlík- !-Aha už to mám. Hádanky jsou fota dole a měly být očíslované, to mě nějak nevyšlo.
Zdenka Soukupová
24.6.2019 13:08
Taky mě napadá jen stín... Nebo že by mozek? Otazník=otázka; ☺=odpověď; vykřičník=HOTOVO! Ale že bychom museli vzpomínat, že máme mozek, to je divné, že?
Alena Vávrová
24.6.2019 11:51
Myslím, že se má hádat z fotopřílohy. A že to snad ani není jen jedna věc. Na posledním obr. vidím dokonce č....
Dana Puchalská
24.6.2019 11:43
A mám hádat přílohy nebo titulní fotku? :-)
Libor Farský
24.6.2019 11:20
Vidím za tou kresbou se smajlíkem nějaké upravené říkadlo či přísloví. Něco jako "Nedáš? :-) Dostaneš!
Zuzana Pivcová
24.6.2019 11:13
Vpravo vidím i vzoreček, vlevo nějaké chlupy?? Deka? Jsem bez fantazie.
JSTE TU POPRVÉ?
Přečtěte si, co všechno portál i60 nabízí.
Chcete na portál i60 přispívat vlastními články, povídat si na chatu, najít nové přátele či partnera v Seznamce?
-
FOTBALOVÁ TIPOVAČKA
-
Kvíz i60 - 23. týden
Tento týden odstartuje Mistrovství světa ve fotbale. Historie a současnost světového fotbalu bude i…
- Foto dne
Aktuální anketa
Máte rádi změny?